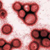

SÓLO SERIES

LAS SERIES MÁS... vistas / adictivas / descargadas

LAS SERIES VUELVEN... ¿PERO CUÁNDO?

SMALLVILLE: Novena temporada: el kriptoniano oscuro

HEROES: Buscando redención

LOST: Ya queda "poco" para dejar de estar perdidos

HOUSE M.D.: Cuando el médico se convierte en paciente

THE BIG BANG THEORY: Después del ártico

CHUCK: Salvada por los fans

FLASH FORWARD y V: Las sucesoras de Lost

RECORDANDO A: Buffy Cazavampiros

THE CW: TV to talk about

ABC: Eastwick, The deep end, The forgotten, Cougar Town

CBS: NCIS: LA, Miami trauma, Accidentally on purpose

FOX: Glee, The Cleveland show, Brothers...

NBC: Trauma, Mercy, One day, Parenthood, Community
|
|

PELICULAS

ESTRENOS SEPTIEMBRE 2009: parte 1

ESTRENOS SEPTIEMBRE 2009: parte 2

MÚSICA

NOVEDADES DEL MUNDO DE LA MÚSICA

OASIS SE SEPARA... DE NUEVO

VUELVEN ROBBIE WILLIAMS Y LEONA LEWIS

DEPORTES

FÚTBOL - LIGA ESPAÑOLA: Sigue la lucha de titanes

FÚTBOL INTERNACIONAL: Prohiben al Chelsea fichar en los próximos dos años

BALONCESTO: Ricky Rubio se queda, pero en el Barça

INFORMÁTICA

SOFTWARE LIBRE Vs. SOFTWARE PROPIETARIO: Parte 1

Defensores de "Derechos de autor" contra las redes P2P:
Feudalismo contra el pueblo

DUDAS Y PREGUNTAS CONTESTADAS

VIDEOJUEGOS: Juegos de PSP
|
|

ZONA USUARIO
ZONA DISEÑO GRÁFICO

IMAGENES ORIGINALES

MONTAJES
ZONA DE LETRAS

COMIENZO DE UNA HISTORIA: La puesta de sol

MICRORRELATO: Gracias, perfecto ser

FANFIC: Grandville 1x01: Little Davidson

NOTICIAS
VIRUS H1N1 Y LA GRIPE A: miles de muertos y cientos de miles de afectados

DISNEY COMPRA MARVEL: Se queda con más de 5000 personajes

TEEN CHOICE AWARDS 2009: Ganadores de la tabla de surf

CURIOSIDADES

ADICCIONES FRIKIS: Primer número

LOS GENES EN CONTRA DE LOS HOMBRES: ¿Qué le pasa al cromosoma Y?

INTERESANTE TECNOLOGÍA:
Video en revista de papel

CIENCIA DETRÁS DE LOS HÉROES
|